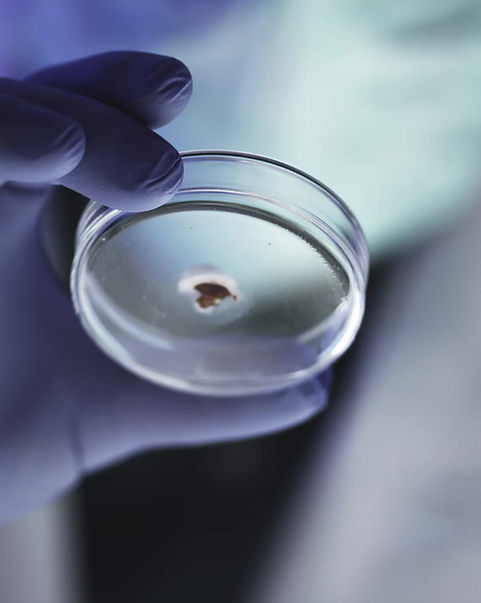

.png)
CLINICAL RESEARCH
CONSULTING & ADVISORY

FOR CROs, SPONSORS & CLINICAL SITES
WHO WE ARE
We are a clinical research consulting company offering services to CROs, Clinical Research Sites, and Sponsors.
We work with clients for a variety of needs including new clinical research site set-up, clinical study design, protocol writing, clinical research marketing and recruitment, clinical research staff training and education and more.

OUR SERVICES
We Provide Comprehensive Consulting Services
CLINICAL STUDY & PROTOCOL DESIGN
We can work in collaboration with your team to design clinical studies and draft a protocol that meets regulatory requirements and scientific standards.

CLINICAL RESEARCH SITE SUPPORT & AUDITING
We can help clinical research sites who are looking to improve their research processes. We can audit to ensure that your site is compliment with the FDA and IRBs.
​
We can also provide training and education for your clinical staff.
Clinical Research Marketing & Recruitment
We offer comprehensive marketing support for clinical trials to help studies meet their enrollment goals quickly and efficiently.


WHY CHOOSE US
Our Approach to Clinical Research Consulting Services
We are committed to providing the best consulting services to our clients. We understand the challenges of clinical development and can help you overcome them. Our approach is based on scientific rigor, regulatory compliance, and operational excellence. We work closely with our clients to understand their needs and provide customized solutions.
OUR PARTNERS
We Work With Leading Companies in the Industry
We collaborate with CROs, clinical research sites, and sponsors to provide the best consulting services to our clients. Our partners include top pharmaceutical and medical device companies.

CLINICAL RESEARCH ORGANIZATIONS
PHARMACEUTICALS
CLINICAL RESEARCH SITES
MEDICAL DEVICE COMPANIES